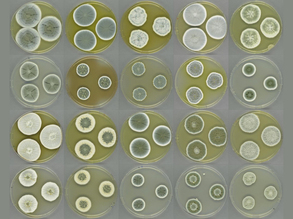

May 2017 Images
- Previous2016
- Jan 17
- Feb 17
- Mar 17
- Apr 17
- May 17
- Jun 17
- Jul 17
- Aug 17
- Sep 17
- Oct 17
- Nov 17
- Dec 17
- 2018Next
-
World No Tobacco Day

-

-
National Smile Month

-

-
Born on this Day – in 1907

-

-

-

-

-

-

-

-
Sound and Vision Week

-
Sound and Vision Week

-
Sound and Vision Week

-
Sound and Vision Week

-
Sound and Vision Week

-

-

-
Mental Health Awareness Week

-
Mental Health Awareness Week

-
Mental Health Awareness Week

-
Mental Health Awareness Week

-
Mental Health Awareness Week

-

-
-

-

-

-

-
